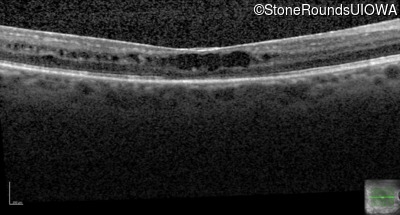
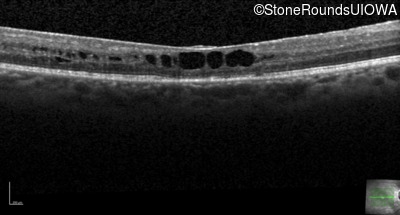
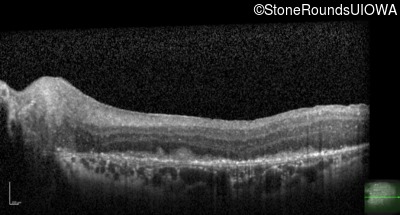
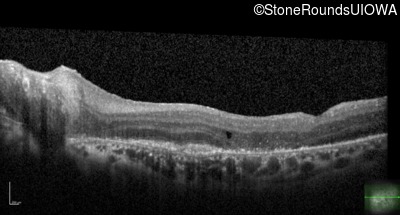
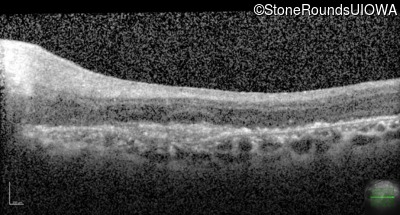

Case
SR61
Student Mode
AD Neovascular Inflammatory Vitreoretinopathy (IIIE3)
Female
Female
Hidden
SR61
Student Mode
AD Neovascular Inflammatory Vitreoretinopathy (IIIE3)
Female
Female
History
This 43 year old woman first experienced a slight loss of visual acuity at age 23. Fluorescein angiography at that time revealed some vascular leakage from the optic discs and peripheral retina. The maximum combined response of the ERG revealed a selective loss of the b-wave.
| Age at visit: 43 years (Visit 3) |
| OD | |||
|---|---|---|---|
| Age at visit: 45 years (Visit 2) |
| Age at visit: 46 years |
| Age at visit: 46 years (Visit 2) |
| OS | |||
|---|---|---|---|
| Age at visit: 46 years (Visit 3) |
| OD | OS | ||
|---|---|---|---|
| OD | OS | ||
|---|---|---|---|
| Age at visit: 46 years (Visit 4) |
| OS | |||
|---|---|---|---|
| Age at visit: 51 years |
Diagnosis & molecular findings
| Disease | Gene | Allele 1 variant(s) | Allele 2 variant(s) | Inheritance mode |
|---|---|---|---|---|
| AD Neovascular Inflammatory Vitreoretinopathy | CAPN5 | Arg243Leu CGC>CTC | AD |
Gene:
Allele 1:
Arg243Leu CGC>CTC
Allele 2:
Inheritance:
AD